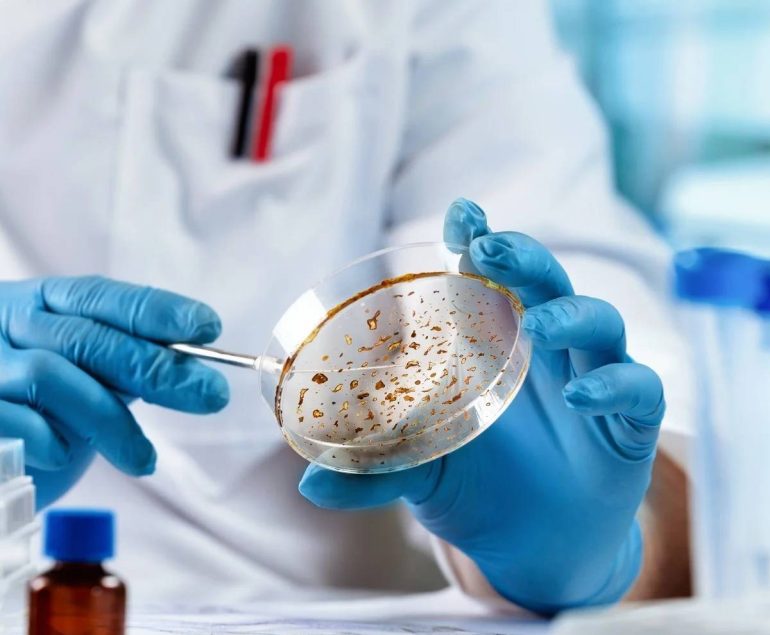

Your reliable source to ensure treatment..
Message from President BADAS
Although this hospital began its journey with limited activities, through the combined efforts and cooperation of everyone, it has now become a fully functional hospital providing advanced medical services at an affordable cost.Â
Message from Director General
I would like to extend a warm welcome and heartfelt thanks for visiting the official website of BIHS General Hospital. Since its inception, BIHS General Hospital has been dedicated to providing quality healthcare with compassion and excellence.
Departments

Internal Medicine
This Brach of Medicine Deals with the Neuromuscular skeletal system that includes pain, rheumatology, neuropathy-paralysis, sports & spine medicine &

Diabetes & Endocrinology
Department of Endocrinology and Metabolism of BIHS started its journey since the inception of

Gastroenterology & Hepatology
Department of Gastroenterology of BIHS General Hospital is a premier center which provides a wide array of multidisciplinary and multi-modality service

Respiratory Medicine
We have seven OT, endoscopic, and colonoscopy procedure rooms. 19 surgeons and gynecologists.

Geriatric Medicine
We have seven OT, endoscopic, and colonoscopy procedure rooms. 19 surgeons and gynecologists.

Nephrology
Department of Nephrology, in GIHS General Hospital is one of the fastest growing units which provides comprehensive nephrology services for outpatien…

Cardiology
Cardiology is a medicine speciality and a branch of internal medicine concerned with disorders of the heart. Cardiology department is an integral part

Clinical Hematology
BIHS general hospital is committed to providing quality full and Authentic biochemical laboratory reports to our patients

Physical Medicine & Rehabilitation
We have seven OT, endoscopic, and colonoscopy procedure rooms. 19 surgeons and gynecologists.

Dermatology
We have seven OT, endoscopic, and colonoscopy procedure rooms. 19 surgeons and gynecologists.

Neuromedicine
Department of Neurosurgery of BIHS General Hospital starting their journey with promising to employs a multidisciplinary approach to providing compreh…

NICU & Pediatrics
We have seven OT, endoscopic, and colonoscopy procedure rooms. 19 surgeons and gynecologists.

Psychiatry & Mental Health
We have seven OT, endoscopic, and colonoscopy procedure rooms. 19 surgeons and gynecologists.


General Surgery
We have seven OT, endoscopic, and colonoscopy procedure rooms. 19 surgeons and gynecologists.

Pediatric Surgery
We have seven OT, endoscopic, and colonoscopy procedure rooms. 19 surgeons and gynecologists.

Foot Care Surgery
We have seven OT, endoscopic, and colonoscopy procedure rooms. 19 surgeons and gynecologists.

Orthopedic Surgery
We have seven OT, endoscopic, and colonoscopy procedure rooms. 19 surgeons and gynecologists.

Ophthalmology
We have seven OT, endoscopic, and colonoscopy procedure rooms. 19 surgeons and gynecologists.

Dental & Maxillofacial Surgery
We have seven OT, endoscopic, and colonoscopy procedure rooms. 19 surgeons and gynecologists.

ENT, Head & Neck Surgery
ENT diseases globally as well as in our country are outnumbered with 53% male and

Obstetrics & Gynecology
The Department of Obstetrics & Gynecology of BIHS General Hospital provides comprehensive services to women in the management of gynecologic and obste

Anaesthesiology
We have seven OT, endoscopic, and colonoscopy procedure rooms. 19 surgeons and gynecologists.
Laboratory Medicine
Welcome to clinical Microbiology laboratory of BIHS General Hospital. Dr Rummana Mazid is currently the Head of clinical Microbiology. She along with

Radiology and Imaging
The department of Radiology & imaging of BIHS General Hospital is one of the most esteemed, comprehensive, and interdisciplinary center serving the ne…

Emergency & Causality
We have seven OT, endoscopic, and colonoscopy procedure rooms. 19 surgeons and gynecologists.

Physiotherapy
We have seven OT, endoscopic, and colonoscopy procedure rooms. 19 surgeons and gynecologists.

Palliative & Home Care
We have seven OT, endoscopic, and colonoscopy procedure rooms. 19 surgeons and gynecologists.

Ambulance Service
We have seven OT, endoscopic, and colonoscopy procedure rooms. 19 surgeons and gynecologists.

Blood Bank
We have seven OT, endoscopic, and colonoscopy procedure rooms. 19 surgeons and gynecologists.

Blood Transfusion
This Brach of Medicine Deals with the Neuromuscular skeletal system that includes pain, rheumatology, neuropathy-paralysis, sports & spine medicine &

Corporate Health Check-up
We have seven OT, endoscopic, and colonoscopy procedure rooms. 19 surgeons and gynecologists.

Home Sample Collection
We have seven OT, endoscopic, and colonoscopy procedure rooms. 19 surgeons and gynecologists.

Clinical Biochemistry
This Brach of Medicine Deals with the Neuromuscular skeletal system that includes pain, rheumatology, neuropathy-paralysis, sports & spine medicine &

Clinical Pathology
This Brach of Medicine Deals with the Neuromuscular skeletal system that includes pain, rheumatology, neuropathy-paralysis, sports & spine medicine &

Immunology & Immunohistochemistry
This Brach of Medicine Deals with the Neuromuscular skeletal system that includes pain, rheumatology, neuropathy-paralysis, sports & spine medicine &

Microbiology
This Brach of Medicine Deals with the Neuromuscular skeletal system that includes pain, rheumatology, neuropathy-paralysis, sports & spine medicine &

Histopathology & Cytology
This Brach of Medicine Deals with the Neuromuscular skeletal system that includes pain, rheumatology, neuropathy-paralysis, sports & spine medicine &
Our Doctor






Dr. Ahmed Salam Mir





National Prof. Dr. A K Azad Khan

Prof. Dr. Md. Nazmul Hoque



Prof. Dr. Tanwir Iqbal Ibn Ahamed









Dr. Muhammad Shahidul Islam Sikder Rumi

Dr. H. N. Masuk Rahman

























Dr. Farzana Hoque Tanmi


Dr. Md. Tarik Immam Hossain Molla














Brig. Gen.(Retd) Prof. Dr. SK. Md. Jaynul Islam



Dr. Rosy Sultana


What we do
A great place for medico hospital center & health care
- Standards of Treatment
- Quality of Care Services
- Well Communication
- Infection Prevention
- Patient Experience
- Quality of Care Services
Testimonials
What people say about medical health care
84%
Happy Patients
I appreciate your hospital really good environment and excellent patient care. You are continuously handle patient treatment wonderfully. Thanks for your great service. Please enjoy the chocolates.

Dr. Sadia Tasnim
I appreciate your hospital really good environment and excellent patient care. You are continuously handle patient treatment wonderfully. Thanks for your great service. Please enjoy the chocolates.

Dr. Fatema Akhter
I appreciate your hospital really good environment and excellent patient care. You are continuously handle patient treatment wonderfully. Thanks for your great service. Please enjoy the chocolates.

Dr. Shamima Sharmin Kanta
Special Service
General Query
Get every single update here med info
Duis aute irure dolor in reprehenderit in voluptate velit esse cillum dolore eu fugiat nulla pariatur excepteur officia deserunt mollit anim id est laborum esse cillum dolore eu fugiat.
Ans:Â is a disease of the pancreas, an organ located behind your stomach. Normally, the pancreas releases a substance called insulin into the blood. Insulin helps the body to use sugars and fats that are broken down from the foods we eat. When a person has diabetes, the pancreas:
- Does not make insulin
- Makes only a little insulin or,
- Makes insulin, but the insulin does not work as it should.
- Family history of diabetes
- African-American, Hispanic, Native American, or Asian-American race or ethnic background Being overweight
- Age (Chances increase with age)
- Taking certain medicines
- Being pregnant
- Pregnancy puts extra stress on a woman’s body which causes some women to develop diabetes. Blood sugar levels often return to normal after childbirth. Yet, women who get diabetes during pregnancy have an increased chance of developing diabetes later in life.
- Type 1 diabetes The pancreas makes little or no insulin. A person with type 1 diabetes must take insulin to survive. This type occurs most often in people who are under 30 years old.
- Type 2 diabetes Insulin is made but it doesn’t work as it should. Nine out of 10 people with diabetes have type 2 diabetes. This type occurs most often in people who are over 40 years old and overweight.
































